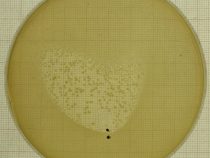

Fúzia je ľahšia, než si myslíte
Keď sa plyn stlačí, ohreje sa – možno to poznáte z dofukovania bicyklovej duše. Keď sa William Thompson, známejší pod menom lord Kelvin, zamyslel nad tým, odkiaľ berie Slnko energiu, objavil sa logický nápad: čo ak sa Slnko jednoducho stláča? Pekný nápad, ale nesedel. Vieme… pokračuj